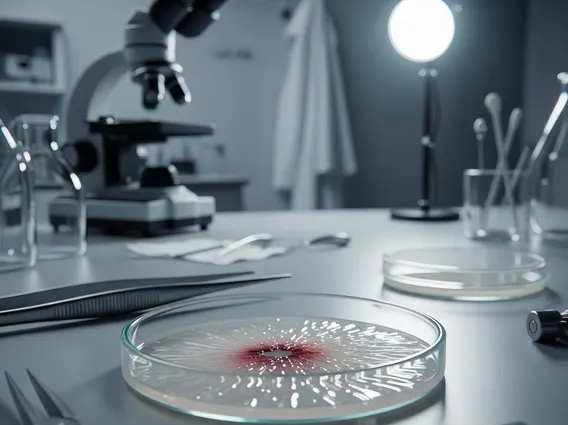
Stage 0 Penile Carcinoma In Situ

Stage 0 Penile Carcinoma In Situ
Stage 0 Penile Carcinoma In Situ (CIS) represents the earliest form of penile cancer, characterized by the presence of abnormal cells confined to the outermost layer of the skin. Understanding this non-invasive condition is crucial for early detection and effective management, offering excellent prognosis when identified promptly.
Key Takeaways
- Stage 0 Penile Carcinoma In Situ (CIS) is a non-invasive cancer, meaning abnormal cells are only on the surface layer of the penis.
- Common penile carcinoma in situ symptoms include reddish patches, lesions, or changes in skin texture, often without pain.
- The definitive diagnosis of stage 0 penile cancer relies on a biopsy of the suspicious area.
- Early treatment for penile carcinoma in situ aims to remove cancerous cells while preserving penile function and appearance.
- Prompt medical attention for any penile skin changes significantly improves outcomes.
What is Stage 0 Penile Carcinoma In Situ (CIS)?
Stage 0 Penile Carcinoma In Situ (CIS) refers to a condition where abnormal, potentially cancerous cells are found exclusively in the epidermis, the outermost layer of the skin of the penis. The term “in situ” literally means “in its original place,” indicating that these cells have not invaded deeper tissues or spread to other parts of the body. This makes CIS a non-invasive form of cancer, distinct from invasive penile cancer where cells have penetrated beyond the epidermis.
Penile cancer, including CIS, is relatively rare in developed countries, accounting for less than 1% of all male cancers. However, CIS represents a significant proportion of early penile cancer diagnoses, highlighting the importance of recognizing its characteristics. When detected at this stage, CIS is highly curable, and treatment typically involves less aggressive interventions compared to more advanced forms of the disease. Risk factors can include human papillomavirus (HPV) infection, poor hygiene, and phimosis (a tight foreskin).
Symptoms of Stage 0 Penile Carcinoma In Situ
The penile carcinoma in situ symptoms can often be subtle and may be mistaken for other benign skin conditions, which sometimes leads to delayed diagnosis. It is important for individuals to be aware of any persistent changes on the penis and seek medical evaluation. Common symptoms include:
- Reddish Patches or Lesions: These can appear as flat, discolored areas, sometimes with a velvety or scaly texture. They may be well-defined or irregular in shape.
- Growths: The presence of small, raised bumps or lesions that do not resolve on their own.
- Changes in Skin Texture: Areas of skin that feel rougher or thicker than the surrounding tissue.
- Discoloration: Variations in skin color, often appearing red, brown, or even whitish.
- Itching or Discomfort: While often painless, some individuals may experience mild itching or irritation in the affected area.
These symptoms typically progress slowly and may remain stable for extended periods. Because they are usually not painful in the early stages, men might overlook them, underscoring the need for regular self-examination and prompt consultation with a healthcare professional for any unusual or persistent penile skin changes.
Diagnosis and Early Treatment for Stage 0 Penile Carcinoma In Situ
The definitive diagnosis of stage 0 penile cancer typically begins with a thorough physical examination by a urologist or dermatologist. During this examination, the doctor will carefully inspect the penis for any suspicious lesions, patches, or growths. However, visual inspection alone is not sufficient for a definitive diagnosis. The gold standard for confirming CIS is a biopsy, where a small tissue sample from the affected area is removed and examined under a microscope by a pathologist. This procedure helps differentiate CIS from other benign conditions and confirms the presence of cancerous cells confined to the epidermis.
Once diagnosed, early treatment for penile carcinoma in situ focuses on eradicating the abnormal cells while preserving the function and cosmetic appearance of the penis. Treatment options are generally minimally invasive and highly effective for CIS:
| Treatment Method | Description | Mechanism |
|---|---|---|
| Topical Chemotherapy | Application of creams containing agents like 5-fluorouracil (5-FU) or imiquimod directly to the lesion. | These agents destroy rapidly dividing cancer cells or stimulate the immune system to attack them. |
| Laser Ablation | Using a focused laser beam to precisely destroy the cancerous cells. | The laser energy vaporizes the abnormal tissue with minimal damage to surrounding healthy skin. |
| Excisional Biopsy | Surgical removal of the lesion along with a small margin of healthy tissue. | Ensures complete removal of the cancerous cells for pathological confirmation of clear margins. |
| Cryotherapy | Freezing the cancerous cells using liquid nitrogen. | The extreme cold destroys the abnormal cells, which then slough off. |
The choice of treatment depends on factors such as the size and location of the lesion, as well as patient preference. Due to the potential for recurrence, regular follow-up appointments are crucial after treatment to monitor for any new or returning lesions, ensuring long-term success and preventing progression to invasive cancer.



















